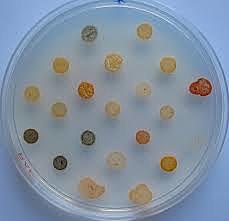
Robert Koch

-
Zacharias Jassen inventa el primer microscopio de dos lentes con ayuda de su padre.
https://www.youtube.com/watch?v=_UgFj9hzcBo -
Descubrió la célula observando en el microscopio un corcho.
-
Descubre los microorganismos a los que llamo minúsculos anima-culos
-
Propuso que el aire transportaba germenes en el tiempo de cultivo
-
Edward Jenner descubrió la vacuna antiviriolica y descubrió nuevas técnicas de vacunación.
-
Descubrió los antisépticos mejorando la situación post operatoria de los pacientes.
-
Primero en asilar microorganismo, descubrió el bacilo de la tuberculosis y se le conoce como el fundador de la microbiología
-
Desarrolló el método de tincion de bacterias con ayuda de anilina para así distinguir bacterias positivas de las negativas
-
Descubre la penicilina, es un moho que produce una sustancia con efectos antibacterianos
-
Descubren que el ADN es el material genético
-
James Watson y Francis Crick hacen este descubrimiento y llegan a la conclusion de que toda la vida existe gracias al ADN
-
Crea la clasificacion taxonomica en 5 reinos
-
Carl Richard Woese crea la nueva taxonomia basada en la comparacion entre especies.
Información sacada de: https://www.youtube.com/watch?v=_UgFj9hzcBo